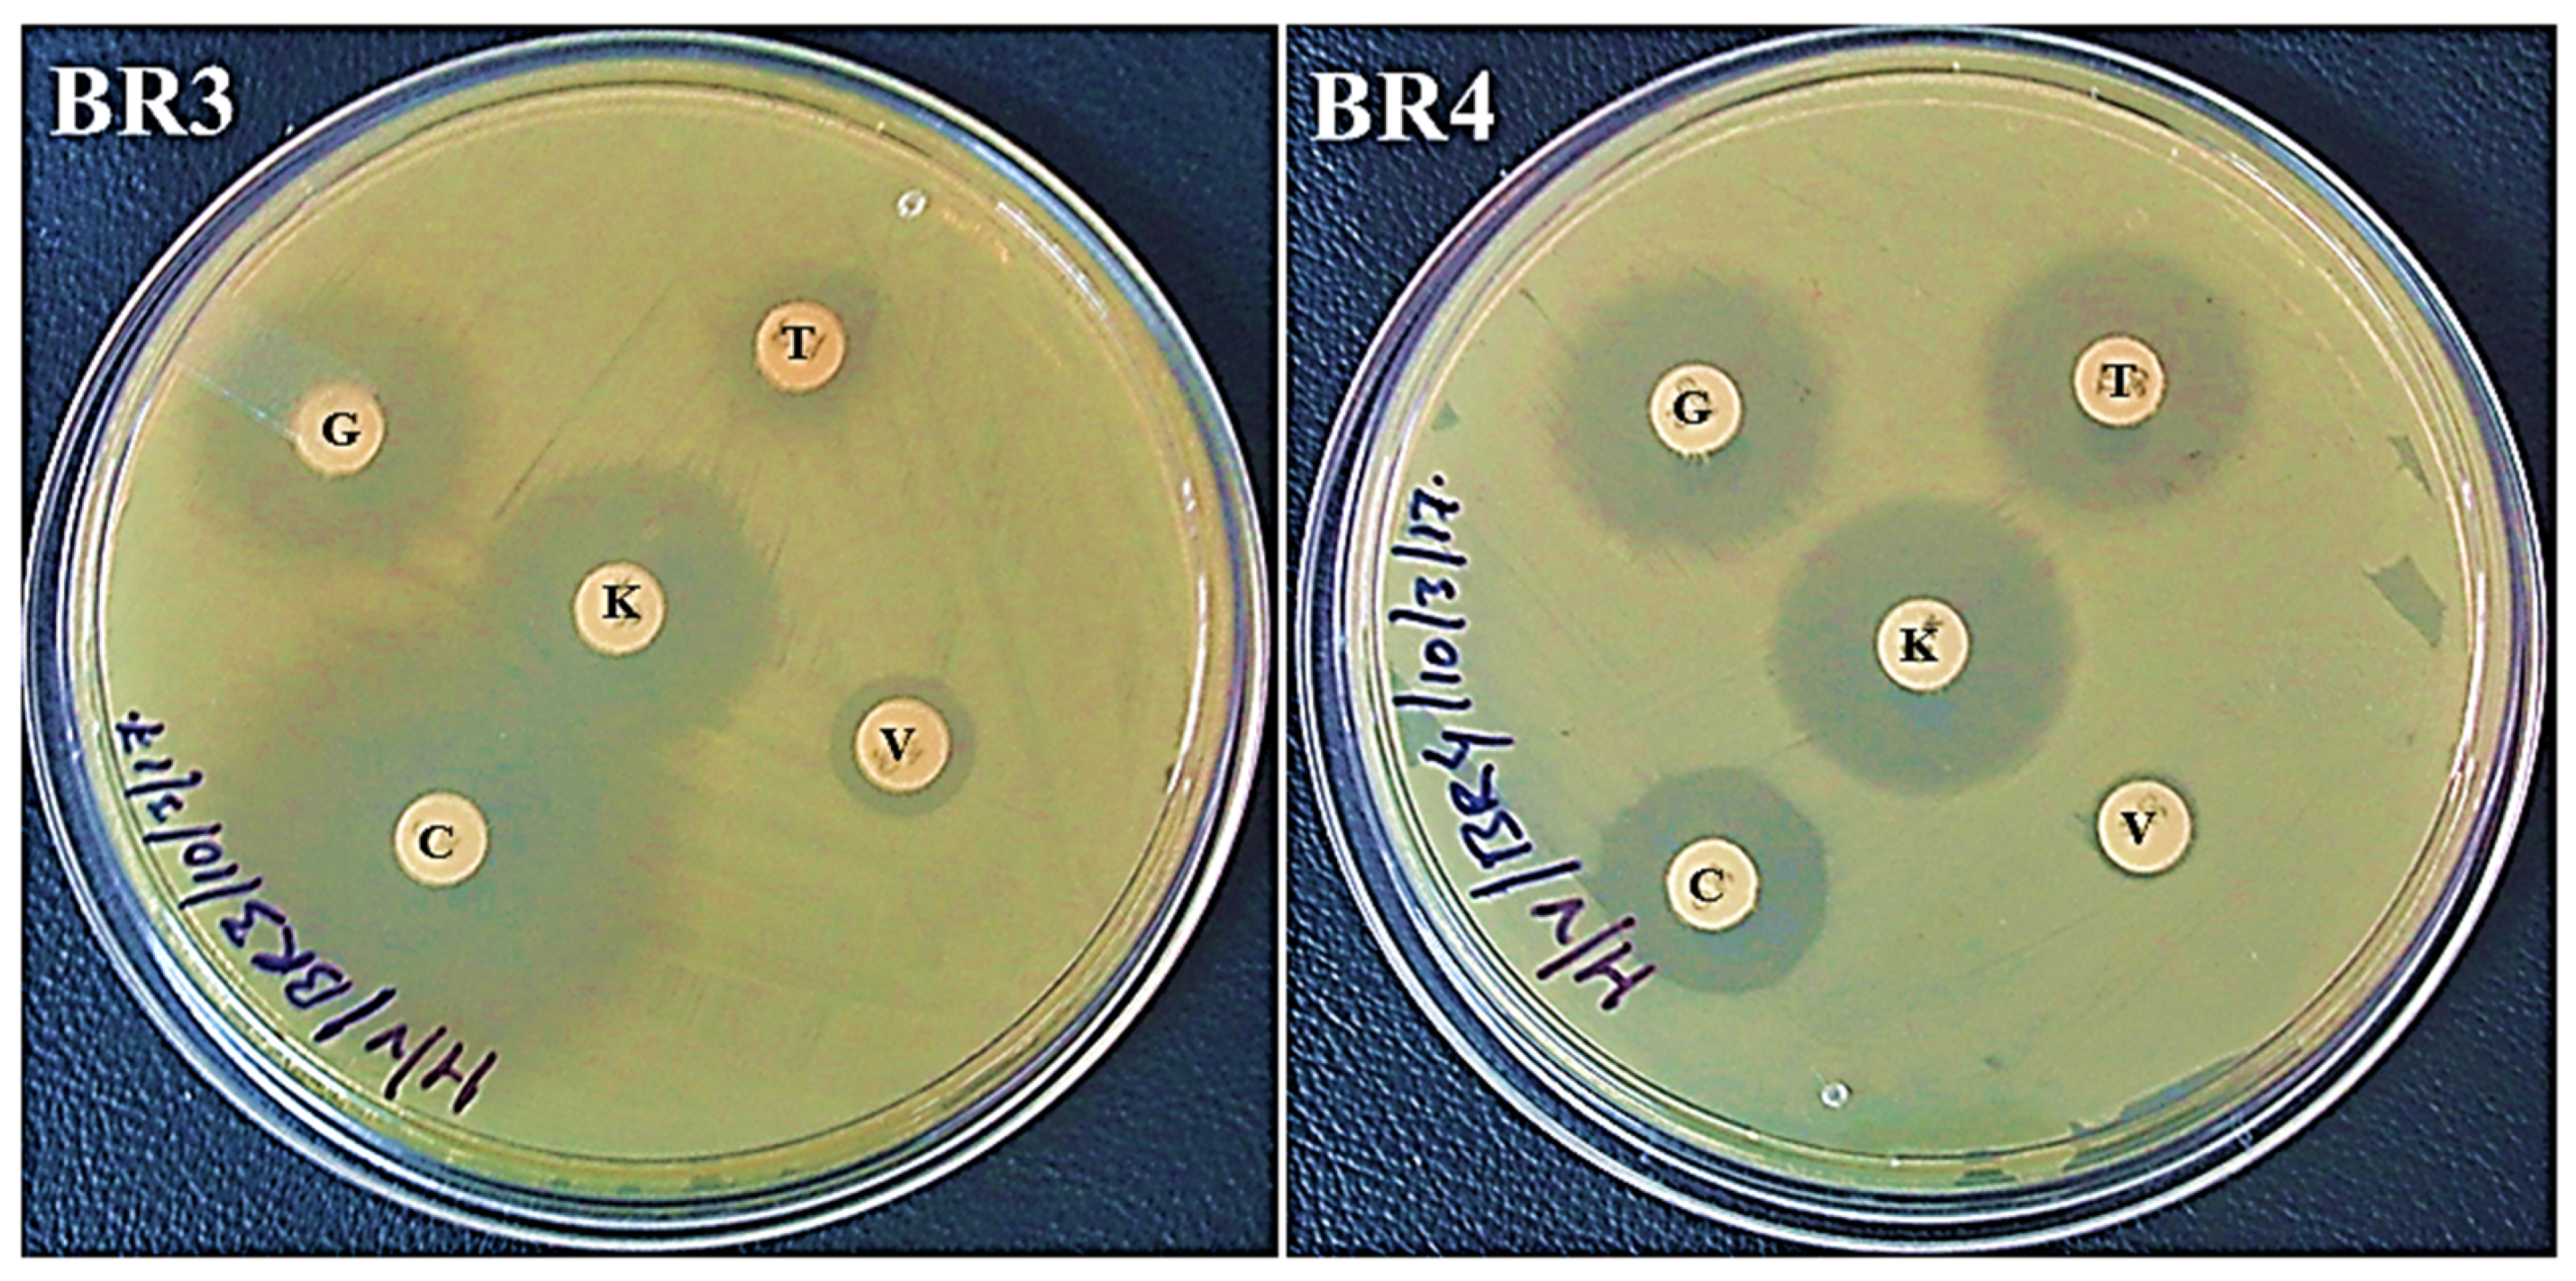
Biotech 11 00004 g003

The Identification of Ethidium Bromide-Degrading Bacteria from Laboratory Gel Electrophoresis Waste
Abstract
1. Introduction
2. Materials and Methods
2.1. Bacterial Isolates and Culture
2.2. Antibiotic Sensitivity Profiling
2.3. Gel Electrophoresis of Crude Bicterial Lysate and Plasmid Preparation
2.4. 16-rRNA Gene Based Phylogenetic Analysis of Bacterial Isolates
2.5. Pathogenic Status of BR3 and BR4
3. Results and Discussion
3.1. Antibiotic Resistance Assay and Gel Electrophoresis of Crude Lysate
3.2. Identification and Phylogenetic Status of Bacterial Isolates
3.3. Pathogenicity Status of the Isolates
4. Conclusions
Author Contributions
Funding
Institutional Review Board Statement
Informed Consent Statement
Data Availability Statement
Acknowledgments
Conflicts of Interest
References
- Burns, V.W.F. Fluorescence decay time characteristics of the complex between ethidium bromide and nucleic acids. Arch. Biochem. Biophys. 1969, 133, 420–424. [Google Scholar] [CrossRef]
- Nafisi, S.; Saboury, A.A.; Keramat, N.; Neault, J.-F.; Tajmir-Riahi, H.-A. Stability and structural features of DNA intercalation with ethidium bromide, acridine orange and methylene blue. J. Mol. Struct. 2007, 827, 35–43. [Google Scholar] [CrossRef]
- Olmsted, J., III; Kearns, D.R. Mechanism of ethidium bromide fluorescence enhancement on binding to nucleic acids. Biochemistry 1977, 16, 3647–3654. [Google Scholar] [CrossRef] [PubMed]
- Lunn, G.; Sansone, E.B. Ethidium bromide: Destruction and decontamination of solutions. Anal. Biochem. 1987, 162, 453–458. [Google Scholar] [CrossRef]
- Zocher, R.; Billich, A.; Keller, U.; Messner, P. Destruction of ethidium bromide in solution by ozonolysis. Biol. Chem. Hoppe-Seyler 1988, 369, 1191–1194. [Google Scholar] [CrossRef]
- Armour, M.A. Hazardous Laboratory Chemicals Disposal Guide, 3rd ed.; CRC Press: Boca Raton, FL, USA, 2003; pp. 256–257. [Google Scholar]
- Joshua, H. Quantitative adsorption of ethidium-bromide from aqueous-solutions by macroreticular resins. Biotechniques 1986, 4, 207–208. Available online: https://Biotechniques.org/Quantitative-adsorption-of-ethidium-bromide-from-aqueous-solutions-by-macroreticular-resins (accessed on 28 July 2020).
- Sigma-Aldrich and Merck. Ethidium Bromide—Product Information Sheet. Available online: https://www.sigmaaldrich.com/content/dam/sigma-aldrich/docs/Sigma/Product_Information_Sheet/e7637pis.pdf (accessed on 29 July 2020).
- Xie, E.; Zheng, L.; Ding, A.; Zhang, D. Mechanisms and pathways of ethidium bromide Fenton-like degradation by reusable magnetic nanocatalysts. Chemosphere 2021, 262, 127852. [Google Scholar] [CrossRef]
- Sukhumungoon, P.; Rattanachuay, P.; Hayeebilan, F.; Kantachote, D. Biodegradation of ethidium bromide by Bacillus thuringiensis isolated from soil. Afr. J. Microbiol. Res. 2013, 7, 471–476. Available online: https://academicjournals.org/journal/AJMR/article-full-text-pdf/6F49CBE19946 (accessed on 28 July 2020).
- Lone, T.A.; Revathi, C.; Lone, R.A. Isolation of dye degrading Bacillus species from the soil near dyeing industry and its potential application in dye effluent treatment. Am.-Eurasian J. Toxicol. Sci. 2015, 7, 129–135. [Google Scholar] [CrossRef]
- Patil, S.M.; Berde, C.V. Biodegradation of carcinogenic dye, ethidium bromide, by soil microorganisms. World J. Pharm. Pharm. Sci. 2015, 4, 1210–1219. Available online: https://storage.googleapis.com/journal-uploads/wjpps/article_issue/1435661544.pdf. (accessed on 28 July 2020).
- Kumar, A.; Swarupa, P.; Gandhi, V.P.; Kumari, S. Isolation of Ethidium Bromide Degrading Bacteria from Jharkhand. Int. J Appl. Sci. Biotechnol. 2017, 5, 293–301. [Google Scholar] [CrossRef]
- Stanbury, P.F.; Whitaker, A.; Hall, S.J. Principles of Fermentation Technology, 2nd ed.; Elsevier Sciences: Oxford, UK, 2013. [Google Scholar]
- Liu, H.; Zhu, J.; Hu, Q.; Rao, X. Morganella morganii, a non-negligent opportunistic pathogen. Int. J. Infect. Dis. 2016, 50, 10–17. [Google Scholar] [CrossRef] [PubMed]
- Razalski, A.; Sidorczyk, Z.; Kotea, K. Potential virulence factors of Proteus bacilli. Microbiol. Mol. Biol. Rev. 1997, 61, 65–89. Available online: https://Microbiologyandmolecularbiologyreview.org/Potential-virulence-factors-of-Proteus-bacilli (accessed on 25 July 2020).
- Bauer, A.W.; Kirby, W.M.M.; Sherris, J.C.; Turck, M.M. Antibiotic susceptibility testing by a standardized single disk method. Am. J. Clin. Pathol. 1966, 45, 493–496. [Google Scholar] [CrossRef]
- Wayne, P.A. Performance Standards for Antimicrobial Susceptibility Testing; Twenty-Fifth Informational Supplement, CLSI Document M100-S25; Clinical and Laboratory Standards Institute: Malvern, PA, USA, 2015. [Google Scholar]
- Sambrook, J.; Russell, D.W. Molecular Cloning: A Laboratory Manual; Cold Spring Harbor Laboratory Press: Long Island, NY, USA, 2001. [Google Scholar]
- Woese, C.R.; Magrum, L.J.; Gupta, R.; Siegel, R.B.; Stahl, D.A.; Kop, J.; Crawford, N.; Brosius, R.; Gutell, R.; Hogan, J.J.; et al. Secondary structure model for bacterial 16S ribosomal RNA: Phylogenetic, enzymatic and chemical evidence. Nucleic Acids Res. 1980, 8, 2275–2294. [Google Scholar] [CrossRef]
- Gandhi, V.P.; Kumar, A. Isolation and Characterization of Microcystin Degrading Bacteria from Holy Ponds in India. Int. J. Appl. Sci. Biotechnol. 2016, 4, 436–447. [Google Scholar] [CrossRef][Green Version]
- Hall, T. BioEdit: A user-friendly biological sequence alignment editor and analysis program for Windows 95/98/NT. Nucleic Acids Symp. Ser. 1999, 41, 95–98. [Google Scholar]
- Huang, X.; Madan, A. CAP3: A DNA sequence assembly program. Genome Res. 1999, 9, 868–877. [Google Scholar] [CrossRef]
- Yoon, S.H.; Ha, S.M.; Kwon, S.; Lim, J.; Kim, Y.; Seo, H.; Chun, J. Introducing EzBioCloud: A taxonomically united database of 16S rRNA gene sequences and whole-genome assemblies. Int. J. Syst. Evol. 2017, 67, 1613–1617. [Google Scholar] [CrossRef]
- Kumar, S.; Stecher, G.; Li, M.; Knyaz, C.; Tamura, K. MEGA X: Molecular Evolutionary Genetics Analysis across Computing Platforms. Mol. Biol. Evol. 2018, 35, 1547–1549. [Google Scholar] [CrossRef]
- Wang, H.F.; Du, L.Y.; Luo, J.; He, H.X. Isolation, identification and characterization of Morganella morganii from Naja naja atra in Beijing, China. Cell. Mol. Biol. 2017, 63, 52–58. [Google Scholar] [CrossRef] [PubMed]
- Dai, H.; Lu, B.; Li, Z.; Huang, Z.; Cai, H.; Yu, K.; Wang, D. Multilocus sequence analysis for the taxonomic updating and identification of the genus Proteus and reclassification of Proteus genospecies 5 O’Hara et al. 2000, Proteus cibarius Hyun et al. 2016 as later heterotypic synonyms of Proteus terrae Behrendt et al. 2015. BMC Microbiol. 2020, 20, 152. [Google Scholar] [CrossRef]
- Classification of Microorganisms by Risk Group, UNSW, Australia. Available online: https://safety.unsw.edu.au/sites/default/files/HS076_Classification_of_infective_microorganisms.pdf (accessed on 29 July 2020).
- Chung, T.H.; Yi, S.W.; Kim, B.S.; Kim, W.I.; Shin, G.W. Identification and antibiotic resistance profiling of bacterial isolates from septicaemic soft-shelled turtles (Pelodiscus sinensis). Veterinární Med. 2017, 62, 169–177. [Google Scholar] [CrossRef]
- Behrendt, U.; Augustin, J.R.; Spraer, C.; Gelbrecht, J.; Schumann, P.; Ulrich, A. Taxonomic characterisation of Proteus terrae sp. nov., a N2O-producing, nitrate-ammonifying soil bacterium. Antonie Leeuwenhoek 2015, 108, 1457–1468. [Google Scholar] [CrossRef] [PubMed]
- Yu, X.; Torzewska, A.; Zhang, X.; Yin, Z.; Drzewiecka, D.; Cao, H.; Liu, B.; Knirel, Y.A.; Rozalski, A.; Wang, L. Genetic diversity of the O antigens of Proteus species and the development of a suspension array for molecular serotyping. PLoS ONE 2017, 12, e0183267. [Google Scholar] [CrossRef] [PubMed]

| Diameter (mm) of the Zone of Inhibition Following 24 h of Incubation | |||||
|---|---|---|---|---|---|
| Bacterial Isolates | Antibiotics | ||||
| C | V | T | K | G | |
| BR3 | 32 (S) | 11 (R) | 11 (R) | 23 (S) | 22 (S) |
| BR4 | 16 (I) | <1 (R) | 20 (S) | 22 (S) | 20 (S) |
Publisher’s Note: MDPI stays neutral with regard to jurisdictional claims in published maps and institutional affiliations. |
© 2022 by the authors. Licensee MDPI, Basel, Switzerland. This article is an open access article distributed under the terms and conditions of the Creative Commons Attribution (CC BY) license (https://creativecommons.org/licenses/by/4.0/).
Share and Cite
Gandhi, V.P.; Kesari, K.K.; Kumar, A. The Identification of Ethidium Bromide-Degrading Bacteria from Laboratory Gel Electrophoresis Waste. BioTech 2022, 11, 4. https://doi.org/10.3390/biotech11010004
Gandhi VP, Kesari KK, Kumar A. The Identification of Ethidium Bromide-Degrading Bacteria from Laboratory Gel Electrophoresis Waste. BioTech. 2022; 11(1):4. https://doi.org/10.3390/biotech11010004
Chicago/Turabian StyleGandhi, Vikram Pal, Kavindra Kumar Kesari, and Anil Kumar. 2022. "The Identification of Ethidium Bromide-Degrading Bacteria from Laboratory Gel Electrophoresis Waste" BioTech 11, no. 1: 4. https://doi.org/10.3390/biotech11010004
APA StyleGandhi, V. P., Kesari, K. K., & Kumar, A. (2022). The Identification of Ethidium Bromide-Degrading Bacteria from Laboratory Gel Electrophoresis Waste. BioTech, 11(1), 4. https://doi.org/10.3390/biotech11010004

